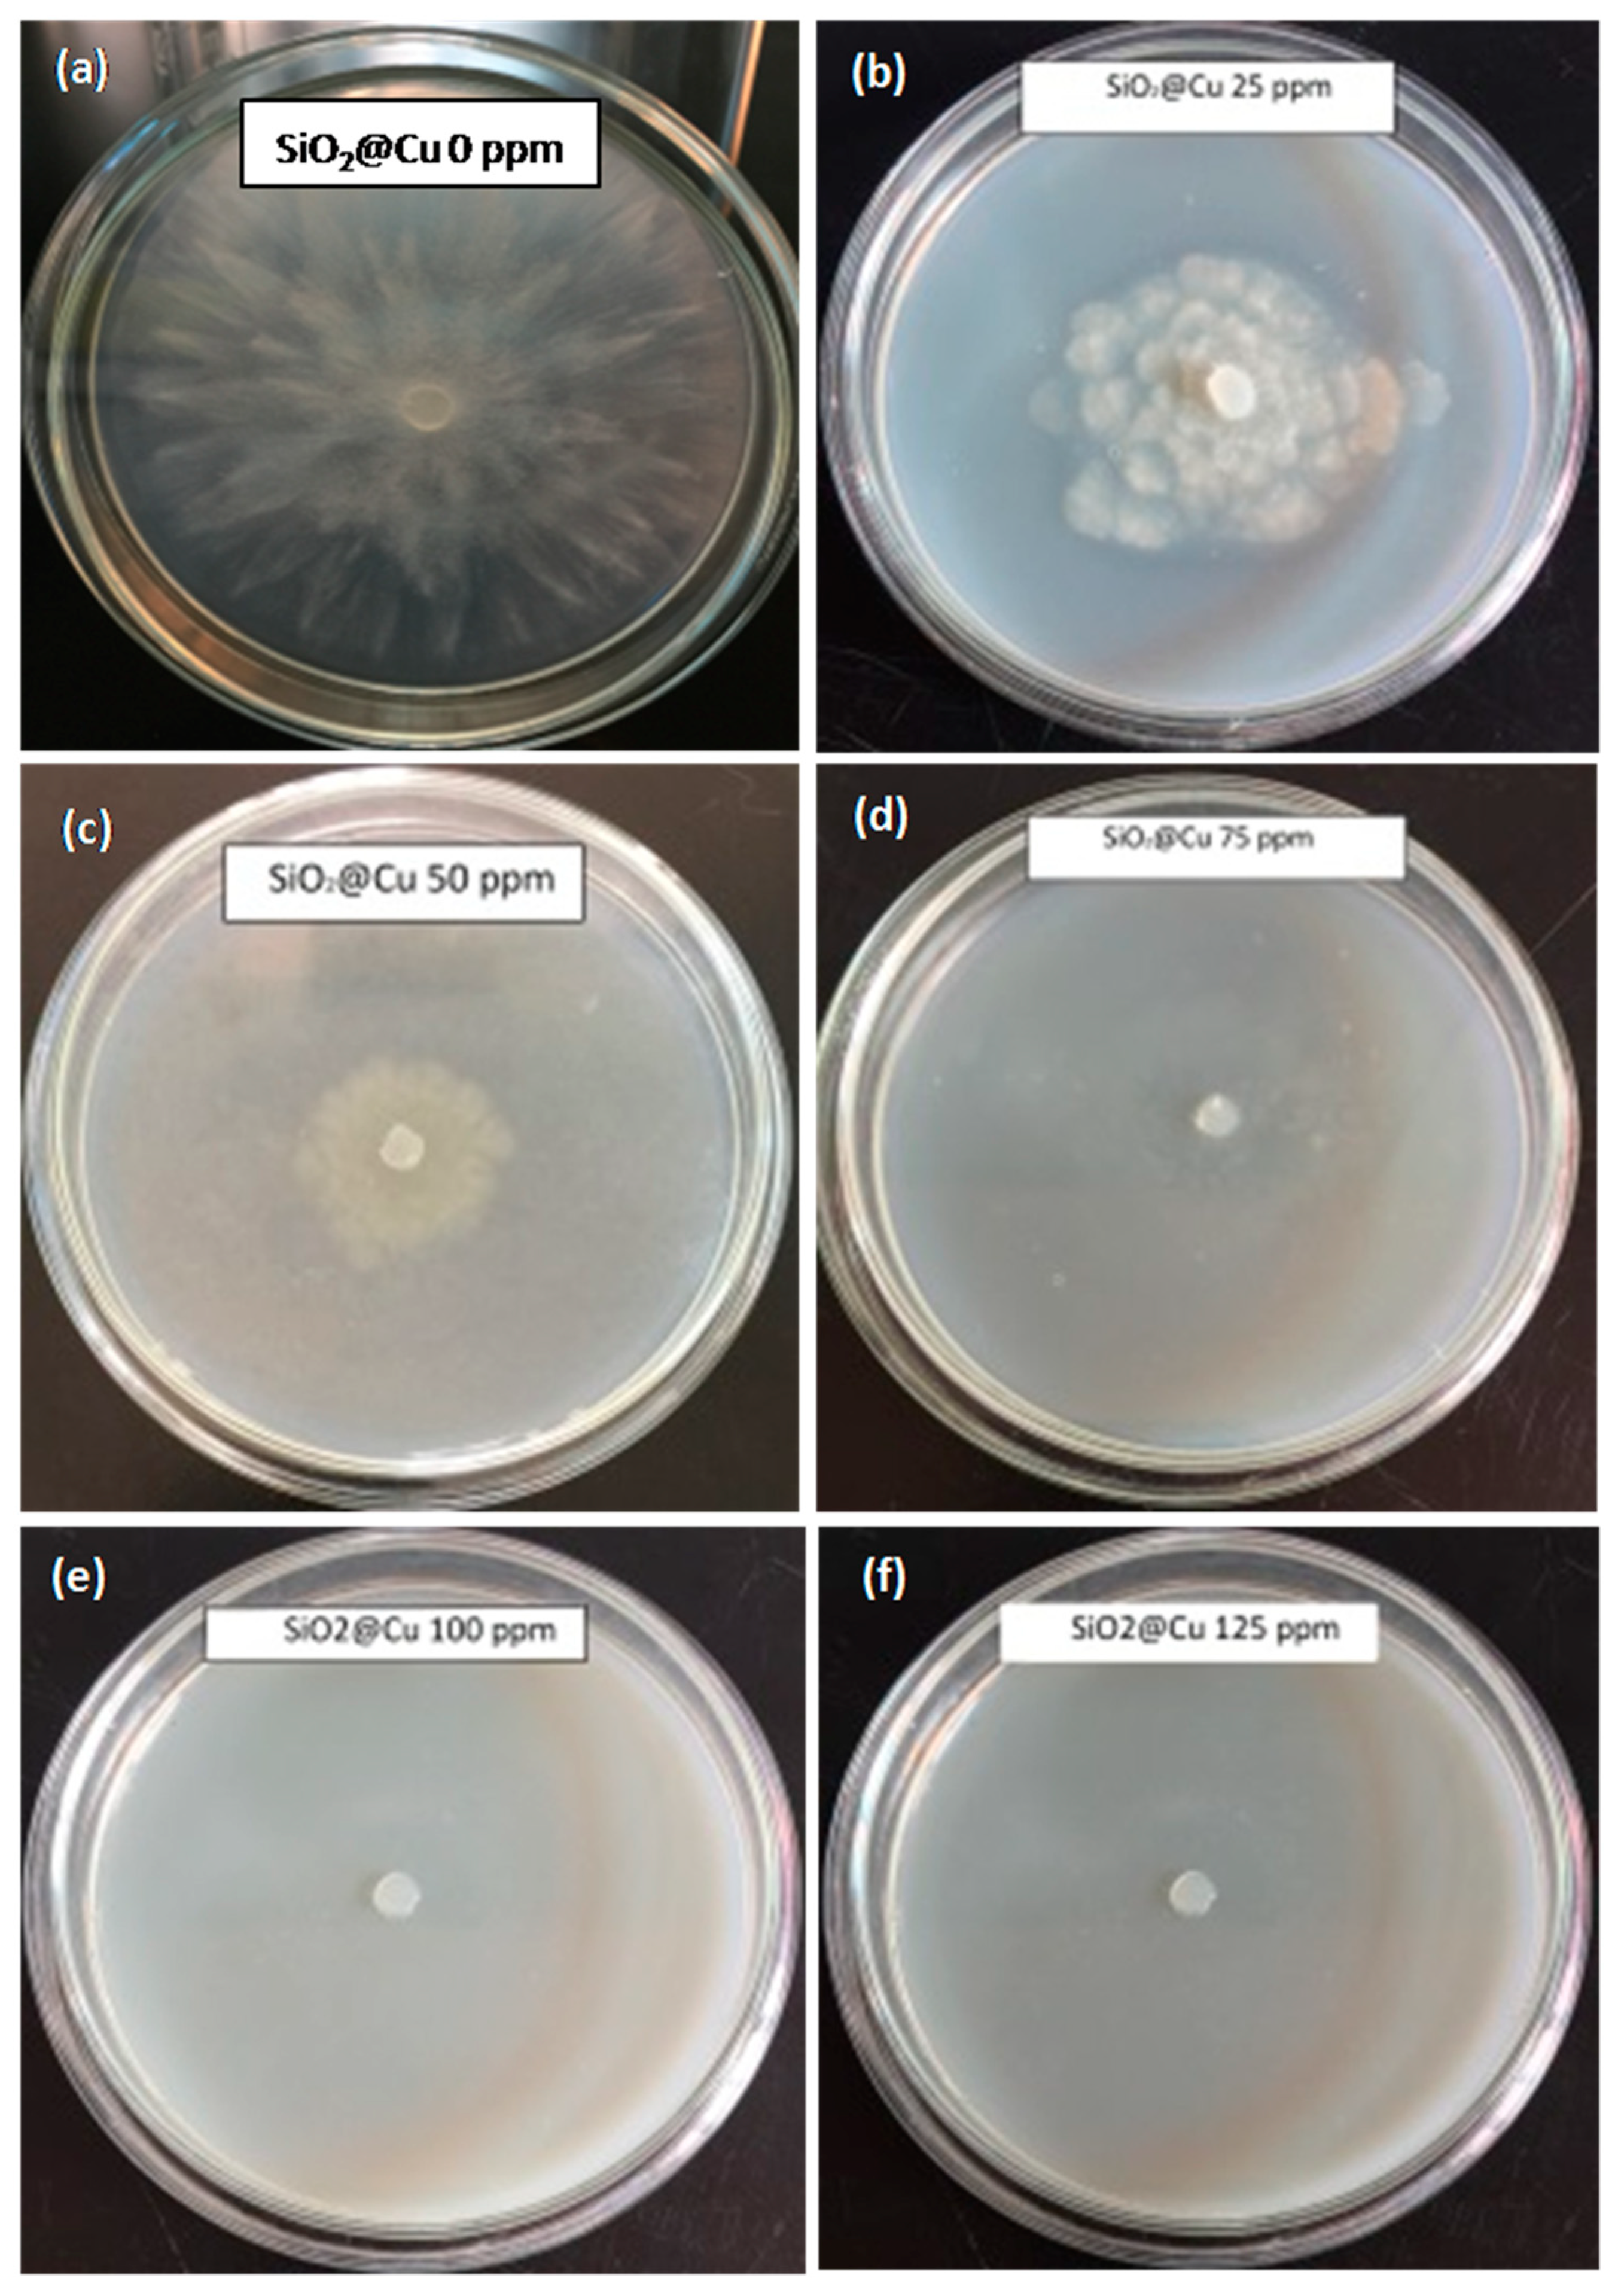
Polymers 13 00888 g007 Polymers 13 00888 g007

Facile Synthesis of Carboxymethyl Cellulose Coated Core/Shell SiO2@Cu Nanoparticles and Their Antifungal Activity against Phytophthora capsici
Abstract
1. Introduction
2. Materials and Methods
2.1. Materials
2.2. Preparation of SiO2@Cu@CMC Nanocomposites
2.3. Material Characterizations
2.4. Phytophthora capsici Preparation
2.5. Antifungal Effect Test on Phytophthora capsici
3. Results and Discussion
3.1. The Stability of the Suspension
3.2. Characteristics of the Obtained Materials
3.3. Antifungal Effect Tests on Phytophthora capsici
4. Conclusions
Author Contributions
Funding
Institutional Review Board Statement
Informed Consent Statement
Data Availability Statement
Conflicts of Interest
References
- Brauer, V.S.; Rezende, C.P.; Pessoni, A.M.; De Paula, R.G.; Rangappa, K.S.; Nayaka, S.C.; Gupta, V.K.; Almeida, F. Antifungal agents in agriculture: Friends and foes of public health. Biomolecules 2019, 9, 521. [Google Scholar] [CrossRef]
- Rai, M.; Ingle, A.P.; Pandit, R.; Paralikar, P.; Shende, S.; Gupta, I.; Biswas, J.K.; da Silva, S.S. Copper and copper nanoparticles: Role in management of insect-pests and pathogenic microbes. Nanotechnol. Rev. 2018, 7, 303–315. [Google Scholar] [CrossRef]
- Giannousi, K.; Avramidis, I.; Dendrinou-Samara, C. Synthesis, characterization and evaluation of copper based nanoparticles as agrochemicals against Phytophthora infestans. RSC Adv. 2013, 3, 21743–21752. [Google Scholar] [CrossRef]
- De Oliveira-Filho, E.C.; Lopes, R.M.; Paumgartten, F.J.R. Comparative study on the susceptibility of freshwater species to copper-based pesticides. Chemosphere 2004, 56, 369–374. [Google Scholar] [CrossRef] [PubMed]
- Nene, Y.L.; Thapliyal, P.N. Fungicides in Plant Disease Control; International Science Publisher: New York, NY, USA, 1993; ISBN 1881570223. [Google Scholar]
- Diem, P.N.H.; Phuong, T.N.M.; Hien, N.Q.; Quang, D.T.; Hoa, T.T.; Cuong, N.D. Silver, Gold, and Silver-Gold Bimetallic Nanoparticle-Decorated Dextran: Facile Synthesis and Versatile Tunability on the Antimicrobial Activity. J. Nanomater. 2020, 2020, 7195048. [Google Scholar] [CrossRef]
- Wang, L.; Hu, C.; Shao, L. The antimicrobial activity of nanoparticles: Present situation and prospects for the future. Int. J. Nanomed. 2017, 12, 1227. [Google Scholar] [CrossRef]
- Nguyen, N.T.; Tran, D.L.; Nguyen, D.C.; Nguyen, T.L.; Ba, T.C.; Nguyen, B.H.; Ba, T.D.; Pham, N.H.; Nguyen, D.T.; Tran, T.H.; et al. Facile synthesis of multifunctional Ag/Fe3O4-CS nanocomposites for antibacterial and hyperthermic applications. Curr. Appl. Phys. 2015, 15, 1482–1487. [Google Scholar] [CrossRef]
- Gill, H.K.; Garg, H. Pesticide: Environmental impacts and management strategies. Pestic. Asp. 2014, 8, 187. [Google Scholar]
- Nezhad, S.S.; Khorasgani, M.R.; Emtiazi, G.; Yaghoobi, M.M.; Shakeri, S. Isolation of copper oxide (CuO) nanoparticles resistant Pseudomonas strains from soil and investigation on possible mechanism for resistance. World J. Microbiol. Biotechnol. 2014, 30, 809–817. [Google Scholar] [CrossRef]
- Holubnycha, V.; Pogorielov, M.; Korniienko, V.; Kalinkevych, O.; Ivashchenko, O.; Peplinska, B.; Jarek, M. Antibacterial activity of the new copper nanoparticles and Cu NPs/chitosan solution. In Proceedings of the 2017 IEEE 7th International Conference Nanomaterials: Application & Properties (NAP), Zatoka, Ukraine, 10–15 September 2017; IEEE: Piscataway, NJ, USA, 2017; p. 04NB10-1. [Google Scholar]
- Datta, K.K.R.; Kulkarni, C.; Eswaramoorthy, M. Aminoclay: A permselective matrix to stabilize copper nanoparticles. Chem. Commun. 2010, 46, 616–618. [Google Scholar] [CrossRef]
- Kim, Y.H.; Lee, D.K.; Jo, B.G.; Jeong, J.H.; Kang, Y.S. Synthesis of oleate capped Cu nanoparticles by thermal decomposition. Colloids Surf. A Physicochem. Eng. Asp. 2006, 284, 364–368. [Google Scholar] [CrossRef]
- Hambrock, J.; Becker, R.; Birkner, A.; Weiß, J.; Fischer, R.A. A non-aqueous organometallic route to highly monodispersed copper nanoparticles using [Cu(OCH(Me)CH2NMe2)2]. Chem. Commun. 2002, 68–69. [Google Scholar] [CrossRef] [PubMed]
- Chen, L.; Zhang, D.; Chen, J.; Zhou, H.; Wan, H. The use of CTAB to control the size of copper nanoparticles and the concentration of alkylthiols on their surfaces. Mater. Sci. Eng. A 2006, 415, 156–161. [Google Scholar] [CrossRef]
- Athawale, A.A.; Katre, P.P.; Kumar, M.; Majumdar, M.B. Synthesis of CTAB–IPA reduced copper nanoparticles. Mater. Chem. Phys. 2005, 91, 507–512. [Google Scholar] [CrossRef]
- Ziegler, K.J.; Doty, R.C.; Johnston, K.P.; Korgel, B.A. Synthesis of organic monolayer-stabilized copper nanocrystals in supercritical water. J. Am. Chem. Soc. 2001, 123, 7797–7803. [Google Scholar] [CrossRef] [PubMed]
- Haram, S.K.; Mahadeshwar, A.R.; Dixit, S.G. Synthesis and characterization of copper sulfide nanoparticles in Triton-X 100 water-in-oil microemulsions. J. Phys. Chem. 1996, 100, 5868–5873. [Google Scholar] [CrossRef]
- Lisiecki, I.; Bjoerling, M.; Motte, L.; Ninham, B.; Pileni, M.P. Synthesis of copper nanosize particles in anionic reverse micelles: Effect of the addition of a cationic surfactant on the size of the crystallites. Langmuir 1995, 11, 2385–2392. [Google Scholar] [CrossRef]
- Ponce, A.A.; Klabunde, K.J. Chemical and catalytic activity of copper nanoparticles prepared via metal vapor synthesis. J. Mol. Catal. A Chem. 2005, 225, 1–6. [Google Scholar] [CrossRef]
- Haas, I.; Shanmugam, S.; Gedanken, A. Pulsed sonoelectrochemical synthesis of size-controlled copper nanoparticles stabilized by poly (N-vinylpyrrolidone). J. Phys. Chem. B 2006, 110, 16947–16952. [Google Scholar] [CrossRef]
- Tan, K.S.; Cheong, K.Y. Advances of Ag, Cu, and Ag-Cu alloy nanoparticles synthesized via chemical reduction route. J. Nanopart. Res. 2013, 15, 1537. [Google Scholar] [CrossRef]
- Wang, J.; Somasundaran, P. Adsorption and conformation of carboxymethyl cellulose at solid–liquid interfaces using spectroscopic, AFM and allied techniques. J. Colloid Interface Sci. 2005, 291, 75–83. [Google Scholar] [CrossRef]
- Asl, S.A.; Mousavi, M.; Labbafi, M. Synthesis and characterization of carboxymethyl cellulose from sugarcane bagasse. J. Food Process. Technol. 2017, 8, 687. [Google Scholar]
- Nguyen, V.L. Spread of Phytophthora capsici in Black Pepper (Piper nigrum) in Vietnam. Engineering 2015, 7, 506–513. [Google Scholar] [CrossRef]
- Kueh, T.K.; Gumbek, M.; Wong, T.H.; Chin, S.P. A Field Guide to Diseases, Pests and Nutritional Disorders of Black Pepper in Sarawak; Agricultural Research Centre Semongok, Department of Agriculture Kuching, Lee Ming Press Company: Sarawak, Malaysia, 1993. [Google Scholar]
- Truong, N.-V.; Burgress, L.W.; Liew, E.C.Y. Prevalence and aetiology of Phytophthora foot rot of black pepper in Vietnam. Australas. Plant Pathol. 2008, 37, 431–442. [Google Scholar] [CrossRef]
- Pavía, S.P.F.; Biles, C.L.; Waugh, M.E.; Waugh, K.O.; Alvarado, G.R.; Liddell, C.M. Characterization of southern New Mexico Phytophthora capsici Leonian isolates from pepper (Capsicum annuum L.). Rev. Mex. Fitopatol. 2004, 22, 82–89. [Google Scholar]
- Sankar, S.; Sharma, S.K.; Kaur, N.; Lee, B.; Kim, D.Y.; Lee, S.; Jung, H. Biogenerated silica nanoparticles synthesized from sticky, red, and brown rice husk ashes by a chemical method. Ceram. Int. 2016, 42, 4875–4885. [Google Scholar] [CrossRef]
- Anh Tuan, L.N.; Kim Dung, L.T.; Thanh Ha, L.D.; Hien, N.Q.; Van Phu, D.; Du, B.D. Preparation and characterization of nanosilica from rice husk ash by chemical treatment combined with calcination. Vietnam J. Chem. 2017, 55, 455–459. [Google Scholar] [CrossRef]
- Drenth, A.; Sendall, B. Practical guide to detection and identification of Phytophthora. Trop. Plant Prot. 2001, 1, 32–33. [Google Scholar]
- Elamawi, R.M.A.; El-Shafey, R.A.S. Inhibition Effects of Silver Nanoparticles against Rice Blast Disease Caused By Magnaporthe grisea. Egypt. J. Agric. Res 2013, 91, 1271–1281. [Google Scholar]
- Ramyadevi, J.; Jeyasubramanian, K.; Marikani, A.; Rajakumar, G.; Rahuman, A.A.; Santhoshkumar, T.; Kirthi, A.V.; Jayaseelan, C.; Marimuthu, S. Copper nanoparticles synthesized by polyol process used to control hematophagous parasites. Parasitol. Res. 2011, 109, 1403–1415. [Google Scholar] [CrossRef]
- Dong, C.; Cai, H.; Zhang, X.; Cao, C. Synthesis and characterization of monodisperse copper nanoparticles using gum acacia. Phys. E Low Dimens. Syst. Nanostruct. 2014, 57, 12–20. [Google Scholar] [CrossRef]
- Martınez, J.R.; Ruiz, F.; Vorobiev, Y.V.; Pérez-Robles, F.; González-Hernández, J. Infrared spectroscopy analysis of the local atomic structure in silica prepared by sol-gel. J. Chem. Phys. 1998, 109, 7511–7514. [Google Scholar] [CrossRef]
- Wang, W.; Martin, J.C.; Zhang, N.; Ma, C.; Han, A.; Sun, L. Harvesting silica nanoparticles from rice husks. J. Nanopart. Res. 2011, 13, 6981–6990. [Google Scholar] [CrossRef]
- Tran, T.N.; Pham, T.V.A.; Le, M.L.P.; Nguyen, T.P.T. Synthesis of amorphous silica and sulfonic acid functionalized silica used as reinforced phase for polymer electrolyte membrane. Adv. Nat. Sci. Nanosci. Nanotechnol. 2013, 4, 45007. [Google Scholar] [CrossRef]
- Furlan, P.Y.; Furlan, A.Y.; Kisslinger, K.; Melcer, M.E.; Shinn, D.W.; Warren, J.B. Water as the Solvent in the Stober Process for Forming Ultrafine Silica Shells on Magnetite Nanoparticles. ACS Sustain. Chem. Eng. 2019, 7, 15578–15584. [Google Scholar] [CrossRef]
- Abbas, M.; Torati, S.R.; Lee, C.S.; Rinaldi, C.; Kim, C.G. Fe3O4/SiO2 core/shell nanocubes: Novel coating approach with tunable silica thickness and enhancement in stability and biocompatibility. J. Nanomed. Nanotechnol. 2014, 5, 1–8. [Google Scholar] [CrossRef]
- SelvaSelvaraj, M.; Sinha, P.K.; Lee, K.; Ahn, I.; Pandurangan, A.; Lee, T.G. Synthesis and characterization of Mn–MCM-41and Zr–Mn-MCM-41. Microporous Mesoporous Mater. 2005, 78, 139–149. [Google Scholar] [CrossRef]
- Worathanakul, P.; Trisuwan, D.; Phatruk, A.; Kongkachuichay, P. Effect of sol–gel synthesis parameters and Cu loading on the physicochemical properties of a new SUZ-4 zeolite. Colloids Surf. A Physicochem. Eng. Asp. 2011, 377, 187–194. [Google Scholar] [CrossRef]
- Haleem, N.; Arshad, M.; Shahid, M.; Tahir, M.A. Synthesis of carboxymethyl cellulose from waste of cotton ginning industry. Carbohydr. Polym. 2014, 113, 249–255. [Google Scholar] [CrossRef]
- Truong, N.V.; Liew, E.C.Y.; Burgess, L.W. Characterisation of Phytophthora capsici isolates from black pepper in Vietnam. Fungal Biol. 2010, 114, 160–170. [Google Scholar] [CrossRef]
- Xue, J.; Zan, G.; Wu, Q.; Deng, B.; Zhang, Y.; Huang, H.; Zhang, X. Integrated nanotechnology for synergism and degradation of fungicide SOPP using micro/nano-Ag3PO4. Inorg. Chem. Front. 2016, 3, 354–364. [Google Scholar] [CrossRef]
- Velmurugan, P.; Sivakumar, S.; Young-Chae, S.; Seong-Ho, J.; Pyoung-In, Y.; Jeong-Min, S.; Sung-Chul, H. Synthesis and characterization comparison of peanut shell extract silver nanoparticles with commercial silver nanoparticles and their antifungal activity. J. Ind. Eng. Chem. 2015, 31, 51–54. [Google Scholar] [CrossRef]
- Le, V.T.; Bach, L.G.; Pham, T.T.; Le, N.T.T.; Ngoc, U.T.P.; Tran, D.-H.N.; Nguyen, D.H. Synthesis and antifungal activity of chitosan-silver nanocomposite synergize fungicide against Phytophthora capsici. J. Macromol. Sci. Part A 2019, 56, 522–528. [Google Scholar] [CrossRef]
- Pham, N.D.; Duong, M.M.; Le, M.V.; Hoang, H.A.; Pham, L.K.O. Preparation and characterization of antifungal colloidal copper nanoparticles and their antifungal activity against Fusarium oxysporum and Phytophthora capsici. Comptes Rendus Chim. 2019, 22, 786–793. [Google Scholar] [CrossRef]
- Pariona, N.; Mtz-Enriquez, A.I.; Sánchez-Rangel, D.; Carrión, G.; Paraguay-Delgado, F.; Rosas-Saito, G. Green-synthesized copper nanoparticles as a potential antifungal against plant pathogens. RSC Adv. 2019, 9, 18835–18843. [Google Scholar] [CrossRef]

| SiO2@Cu@CMC Concentration (ppm) | P. capsici Inhibition | ||
|---|---|---|---|
| 24 h | 48 h | 72 h | |
| 0 | 0.00 g | 0.00 h | 0.00 h |
| 25 | 49.11 b | 54.78 c | 39.47 c |
| 50 | 84.07 a | 80.05 b | 73.37 b |
| 75 | 84.07 a | 92.34 a | 93.30 a |
| 100 | 84.07 a | 92.34 a | 93.30 a |
| 125 | 84.07 a | 92.34 a | 93.30 a |
| P0.05 | <0.0001 | <0.0001 | <0.0001 |
Publisher’s Note: MDPI stays neutral with regard to jurisdictional claims in published maps and institutional affiliations. |
© 2021 by the authors. Licensee MDPI, Basel, Switzerland. This article is an open access article distributed under the terms and conditions of the Creative Commons Attribution (CC BY) license (http://creativecommons.org/licenses/by/4.0/).
Share and Cite
Hai, N.T.T.; Cuong, N.D.; Quyen, N.T.; Hien, N.Q.; Hien, T.T.D.; Phung, N.T.T.; Toan, D.K.; Huong, N.T.T.; Phu, D.V.; Hoa, T.T. Facile Synthesis of Carboxymethyl Cellulose Coated Core/Shell SiO2@Cu Nanoparticles and Their Antifungal Activity against Phytophthora capsici. Polymers 2021, 13, 888. https://doi.org/10.3390/polym13060888
Hai NTT, Cuong ND, Quyen NT, Hien NQ, Hien TTD, Phung NTT, Toan DK, Huong NTT, Phu DV, Hoa TT. Facile Synthesis of Carboxymethyl Cellulose Coated Core/Shell SiO2@Cu Nanoparticles and Their Antifungal Activity against Phytophthora capsici. Polymers. 2021; 13(6):888. https://doi.org/10.3390/polym13060888
Chicago/Turabian StyleHai, Nguyen Thi Thanh, Nguyen Duc Cuong, Nguyen Tran Quyen, Nguyen Quoc Hien, Tran Thi Dieu Hien, Nguyen Thi Thanh Phung, Dao Khac Toan, Nguyen Thi Thu Huong, Dang Van Phu, and Tran Thai Hoa. 2021. "Facile Synthesis of Carboxymethyl Cellulose Coated Core/Shell SiO2@Cu Nanoparticles and Their Antifungal Activity against Phytophthora capsici" Polymers 13, no. 6: 888. https://doi.org/10.3390/polym13060888
APA StyleHai, N. T. T., Cuong, N. D., Quyen, N. T., Hien, N. Q., Hien, T. T. D., Phung, N. T. T., Toan, D. K., Huong, N. T. T., Phu, D. V., & Hoa, T. T. (2021). Facile Synthesis of Carboxymethyl Cellulose Coated Core/Shell SiO2@Cu Nanoparticles and Their Antifungal Activity against Phytophthora capsici. Polymers, 13(6), 888. https://doi.org/10.3390/polym13060888

